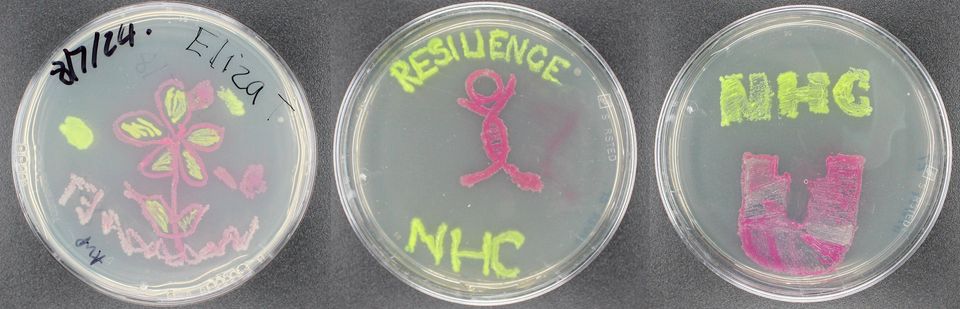

Sixth form student gains experience in real and virtual university research labs
18 July 2024
Thanks to RESILIENCE outreach activity, sixth form student Eliza Thornton from Stokesley Sixth Form College, North Yorkshire, recently spent a week within the research group of Prof Muhammad Safwan Akram at Teesside University learning all about the aseptic techniques required for working to good laboratory practice in both the virtual and the real world.
This involved activities like culturing bacteria, plate streaking and isolating cultures - you can see from the pictures below the creative ways these activities were delivered!
In addition Eliza learnt about important laboratory techniques such as gel electrophoresis and protein purification as well as learning how academic research groups work. Both Bodyswaps soft skills training and FourPlus Immersive cleanroom training were used during the outreach week to engage in both the technical skills and expected behaviours for a career within the sector.
Eliza is pictured below, with Professor Muhammad Safwan Akram and his research group in a group meeting room at Teesside University, and in a training room using virtual reality hardware with National Horizons Centre trainer Stacy Nicholson.

If you are an educator in this field and would like to know more about how RESILIENCE can switch your students onto STEM and the exciting possibilities of a career in medicines manufacturing